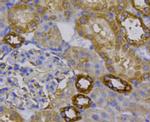
Beta III Tubulin Antibody in Immunohistochemistry (Paraffin) (IHC (P))

Search
Invitrogen
Beta III Tubulin Polyclonal Antibody
{{$productOrderCtrl.translations['antibody.pdp.commerceCard.promotion.promotions']}}
{{$productOrderCtrl.translations['antibody.pdp.commerceCard.promotion.viewpromo']}}
{{$productOrderCtrl.translations['antibody.pdp.commerceCard.promotion.promocode']}}: {{promo.promoCode}} {{promo.promoTitle}} {{promo.promoDescription}}. {{$productOrderCtrl.translations['antibody.pdp.commerceCard.promotion.learnmore']}}
图: 1 / 11
Beta III Tubulin Antibody (PA5-85874) in ICC/IF

产品信息
PA5-85874
已发表种属
宿主/亚型
分类
类型
抗原
偶联物
形式
浓度
保存条件
运输条件
RRID
靶标信息
The betaIII-tubulin isoform is present dominantly in cells of neuronal origin and it is one of the earliest markers of neuronal differentiation. It is regarded as a specific probe for the cells of neuronal origin as well as for the tumours originating from these cells. The betaIII-tubulin is most abundant in cells of neuronal origin, but was also detected in Sertoli cells of the testis and transiently in non-neuronal embryonic tissues.
仅用于科研。不用于诊断过程。未经明确授权不得转售。



